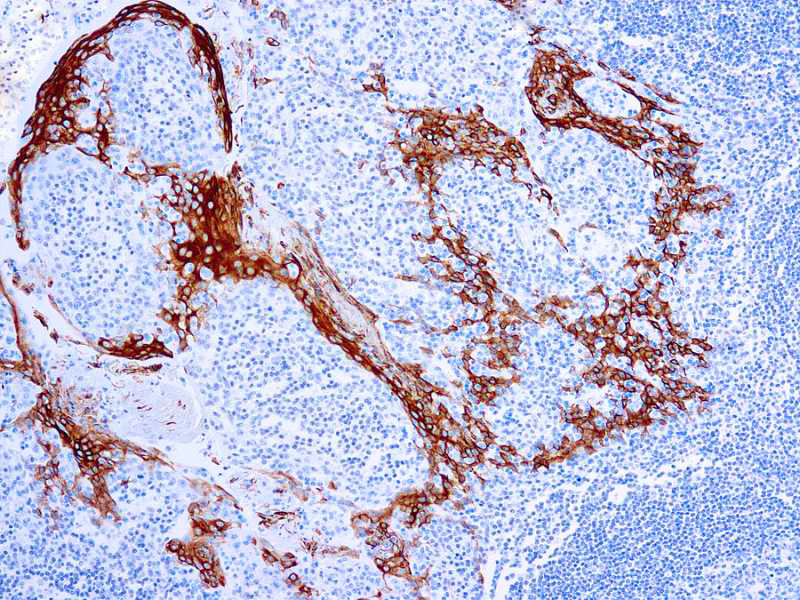

Cytokeratins are a family of intermediate filament proteins that assemble into filaments through forming heterodimers of one type I Cytokeratins (Cytokeratins 9 to 23) and one type II Cytokeratins (keratins 1 to 8). The cytokeratin protein plays a critical role in differentiation, as well as tissue specialization and function, to maintain the overall structural integrity of epithelial cells. Cytokeratins are also useful markers in identifying the origin of metastatic tumors. Cytokeratin 16 is expressed in benign stratified squamous epithelium and squamous cell carcinoma of the head and neck, as well as luminal cells of mammary gland and sweat ducts. It is absent in noninvasive breast carcinomas and normal breast tissue.
Cytokeratin 16
SKU: 8365
Categories: Primary Antibodies, IVD - For U.S. Market, IVD - Outside U.S. Market
Tags: Concentrated, C
Description
Additional information
| Clone | LL025 |
|---|---|
| Isotype | IgG1 |
| Immunogen | BALB/C mice were injected with a synthetic peptide from the C-terminus of human cytokeratin 16. |
| Species | Mouse |
| Cellular Localization | Cytoplasmic |
| Positive Control Tissue | skin, Squamous Cell Carcinoma |
| Pretreatment | EDTA Buffer pD 8.0 |
| Incubation & Temperature | _ |
| Intended Use | IVD |
| Detection System | PolyVue Plus – Two Step Detection System or Montage PolyVue Plus Auto Detection System for Montage 360 System |
| Description/Type | Conc Mouse Monoclonal Antibody |
| Format | Tissue Culture Supernatant |
DATASHEETS & SDS
DATASHEETS & SDS
| Download Datasheet |
| Download SDS Sheet – OSHA |
REFERENCES
REFERENCES
- Markey et al. Br 1 Dermatol 126: 154, 1992.
- Wetzels et al. Am 1 Pathol 138: 751. 1991.
Reviews (0)
Only logged in customers who have purchased this product may leave a review.

Reviews
There are no reviews yet.